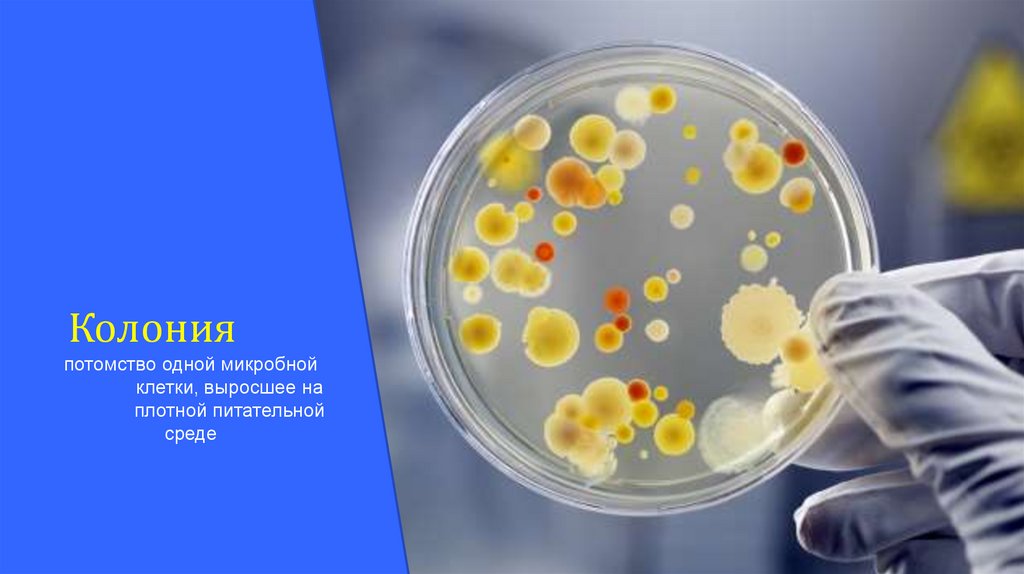
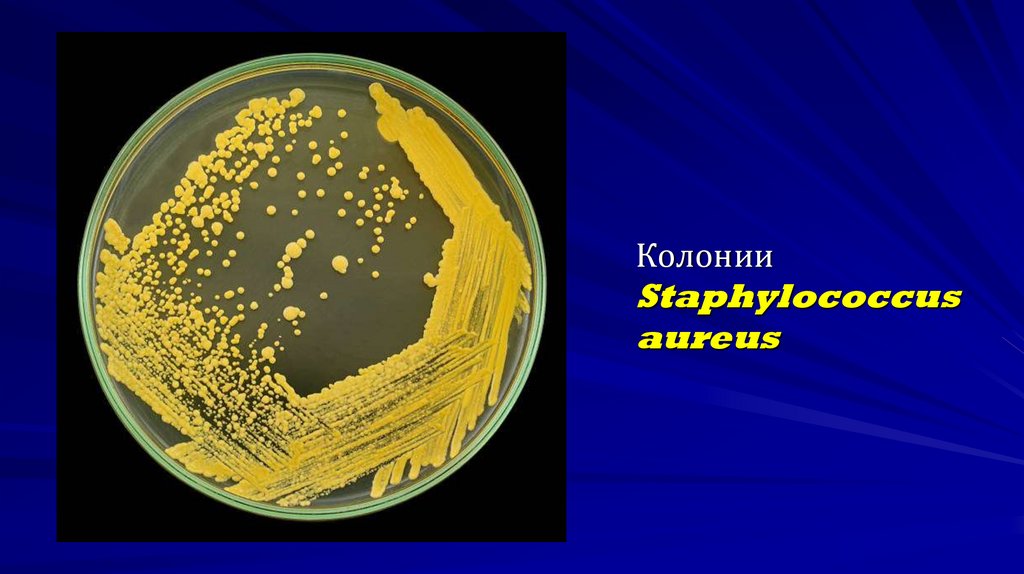
Колонии Staphylococcus aureus
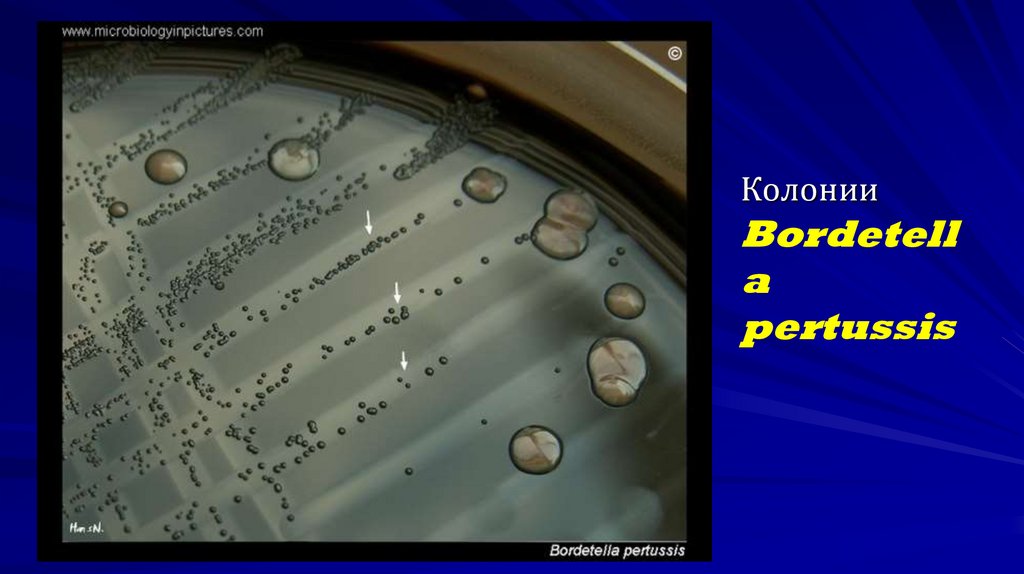
Колонии Bordetella pertussis
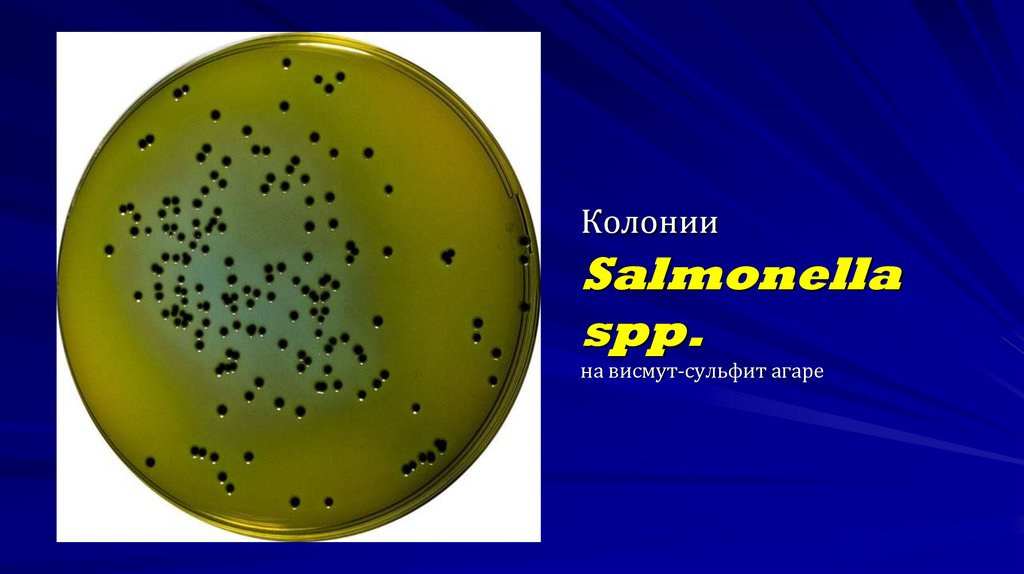
Колонии Salmonella spp. на висмут-сульфит агаре
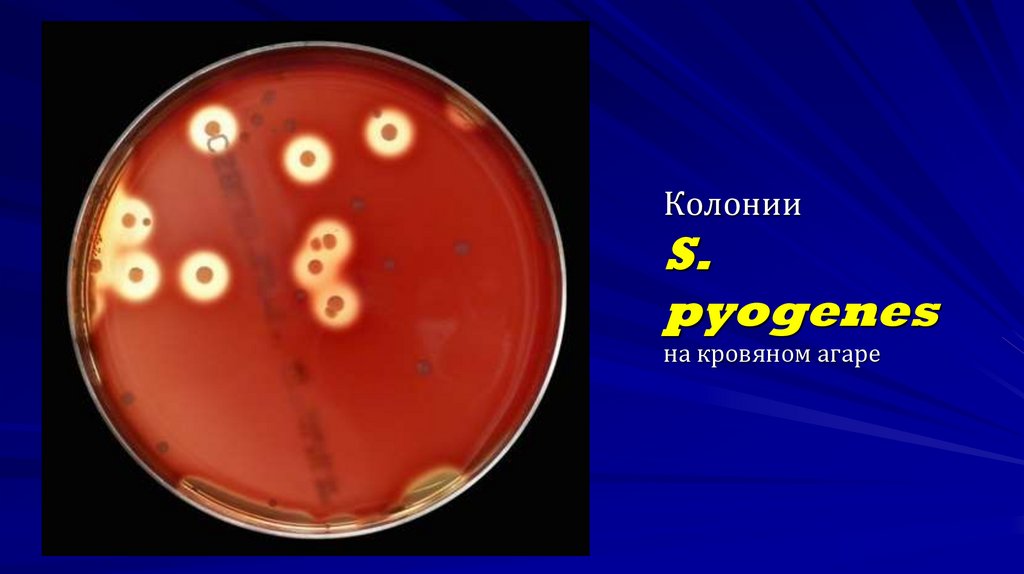
Колонии S. pyogenes на кровяном агаре
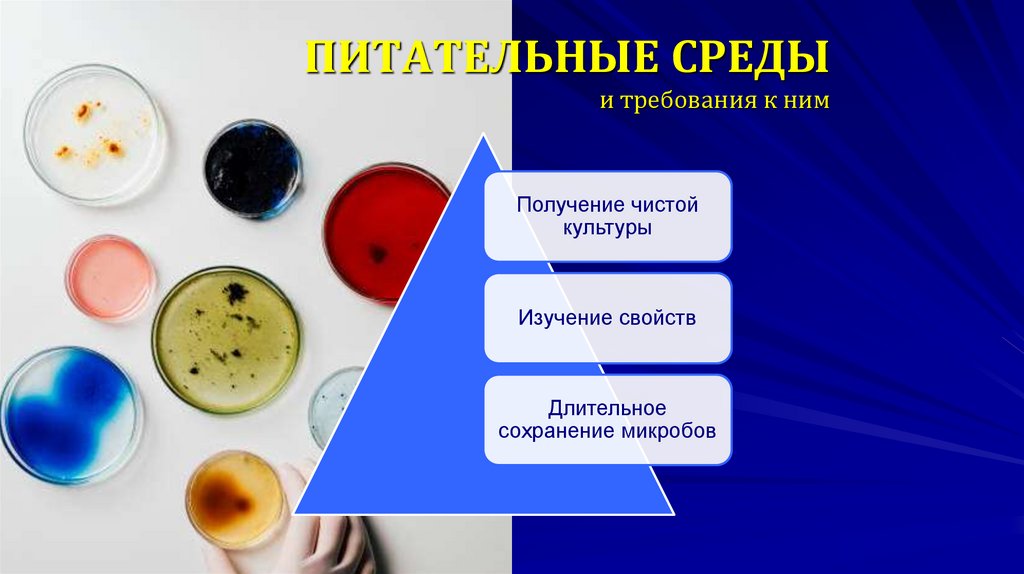
ПИТАТЕЛЬНЫЕ СРЕДЫ и требования к ним
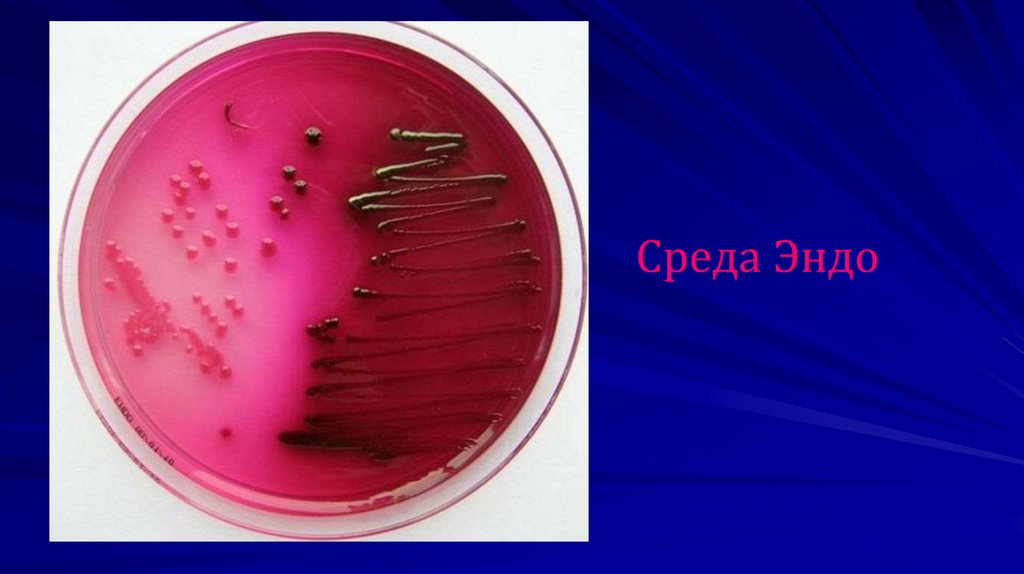

Похожие презентации:
Физиология бактерий
1. ФИЗИОЛОГИЯ БАКТЕРИЙ
Кафедра микробиологии и вирусологииК.м.н., доцент Моисеева А.М.
2.
АНАБОЛИЗМКАТАБОЛИЗМ
3. ПИТАНИЕ БАКТЕРИЙ
600 Да600 Да
Голофитный
способ
питания
4.
МЕХАНИЗМЫ ПИТАНИЯ:простая диффузия
облегченная диффузия
хемиосмотический мембранный транспорт
активный транспорт
транслокация химических групп
5. ТИПЫ ПИТАНИЯ
аутотрофыгетеротрофы
паразиты
облигатные
сапрофиты
факультативные
6.
хемотрофыфототрофы
литотрофы
органотрофы
7.
ауксотрофы – нуждаются в одном или несколькихфакторах роста
прототрофы – могут сами синтезировать факторы роста
из глюкозы и солей аммония
Факторы роста
вещества,
необходимые для роста и размножения микробов: витамины,
аминокислоты, пуриновые и пиримидиновые основания
8. РОСТ И РАЗМНОЖЕНИЕ БАКТЕРИЙ
9. РАЗМНОЖЕНИЕ БАКТЕРИЙ В ЖИДКОЙ ПИТАТЕЛЬНОЙ СРЕДЕ
10. Периодическое культивирование
11.
Колонияпотомство одной микробной
клетки, выросшее на
плотной питательной
среде
12. ХАРАКТЕРИСТИКА КОЛОНИЙ
Рост над поверхностью среды: выпуклые, плоские,куполообразные, вдавленные
Поверхность колоний: гладкая (S-формы) или
шероховатая (R-формы)
Края колоний: ровные или неровные
Форма колоний: круглая, розеткообразная, звездчатая и
др.
Величина колоний: крупные (4-5 мм в диаметре),
средние (2-4 мм), мелкие (1-2 мм) и карликовые (меньше 1
мм)
Консистенция: сухие, слизистые, влажные
Цвет: зависит от наличия пигментов
13. ПИГМЕНТЫ БАКТЕРИЙ
Каротиноидные, растворяются в жирорастворителях (красные, оранжевые,желтые) – микобактерии, сарцины, актиномицеты;
Хиноновые (желтые) – микобактерии туберкулеза;
Меланиновые, нерастворимы в воде, кислотах (черные, коричневые) –
бактероиды, грибы;
Пиррольные (красные) – актиномицеты, Serratia marcescens;
Феназиновые, растворимы в воде (сине-зеленые) – пиоционин синегнойной
палочки. В кислой среде – красный.
Вторичные метаболиты, лучше образуются на свету при 18-200С
защита от УФО, диагностический признак, антибиотическое действие
14. Колонии Staphylococcus aureus
15. Колонии Bordetella pertussis
КолонииBordetell
a
pertussis
16. Колонии Salmonella spp. на висмут-сульфит агаре
17. Колонии S. pyogenes на кровяном агаре
18. ПИТАТЕЛЬНЫЕ СРЕДЫ и требования к ним
Получение чистойкультуры
Изучение свойств
Длительное
сохранение микробов
19. КЛАССИФИКАЦИЯ ПИТАТЕЛЬНЫХ СРЕД
естественные• натуральные продукты животного и
растительного происхождения (молоко,
яйца, сыворотка, кровь)
искусственные
• готовят по определенным рецептам из отваров
животного происхождения с добавлением солей и
пептона
синтетические
•содержат определенные химические
соединения в точно указанных концентрациях
20.
ЖидкиеПолужидкие
Плотные
21.
По назначению:1)
2)
3)
4)
5)
6)
универсальные
специальные
селективные
дифференциально-диагностические
транспортные
среды обогащения
22. Среды Гисса
23.
Среда Эндо24.
К настоящему времени на смену концепциипланктонных форм возбудителя заболеваний
пришли теории ассоциации микробных
сообществ – биопленок
25. Микробные биопленки ответственны за этиологию и патогенез многих острых и, особенно, хронических бактериальных инфекций1,2,3
1.Post J.C., Hiller N.L., Nistico L., et al. The role of biofilms in otolaryngologic infections: update 2007. Curr Opin Otolaryngol Head Neck Surg 2007; 15:347-51.2. Werthen M., Henriksson L, Jensen P.O., et al. An in vitro model of bacterial infections in wounds and other tissues. APMIS 2010; 118:156-64.
3.Manos J. Transcriptome analyses and biofilm-forming characteristics of a clonal Pseudomonas aeruginosa from the cystic fibrosis lung / J. Manos, [et. al.] // J. of Med. Microb.- 2008. –
№57. – P.1454–1465.
26. Структура и микробиологический состав биопленки
Основное внимание сконцентрировано на на двухнеотъемлемых атрибутах биопленки — микробах и
связывающем их в единую систему внеклеточном
матриксе.
1.
Поверхность (биологическая / искусственная)
2.
Кластеры микробных клеток с измененными свойствами:
a.
b.
c.
3.
Параметры роста и дифференциации
Экспрессия специфичных генов
Свои «эндокринная», «выделительная», др. системы
Внеклеточный матрикс:
a.
b.
c.
d.
Экзополисахариды (гликокаликс, «слизистый чехол» и т.д.)
Белки.
Нуклеиновые кислоты.
Другие вещества.
27.
40–95%полисахариды
липиды
до 40%
Полисахаридный матрикс
составляет 85% от всей
биопленки:
белки
до
60%,
нуклеиновые
кислоты до
20%.
Данные соединения находятся в гидратированном
состоянии, 80-90% объема биопленки занимает
вода 16
Moons, P. Bacterial interactions in biofilms / P. Moons [et. al.] // Crit. Rev. Microbiol. – 2009. – Vol. 35, №3. – P. 157–
168.
28. БИОПЛЕНКА созревает уже за 24-48 часов
1. Адгезия бактерий к поверхности.Дренажная
трубка
2. Деление клеток, образование
многоклеточного слоя, синтез
матрикса.
Дренажная
трубка
Бактерии
БИОПЛЕНКА
Отсев бактерий
В течение 2-х ч после контаминации
24-48 ч (созревание биопленки)
Структурно и функционально БИОПЛЕНКА напоминает
многоклеточный организм.
29. СТАДИИ ОБРАЗОВАНИЯ БИОПЛЕНКИ Образование биопленок – комплексный процесс
АДГЕЗИЯАГРЕГАЦИЯ
РОСТ
СОЗРЕВАНИЕ РАСПРОСТРАНЕНИЕ
30.
ЭЛЕКТРОННАЯ МИКРОСКОПИЯ31. МПК90 антибиотиков для планктонных форм S.aureus и бактерий в составе биоплёнки, мкг/мл
600600
Планктонные формы
500
Бактерии в составе БП
400
300
300
200
128
100
2 4,8
0,5 2,2
0,2 2,2
0,2 1,5
16
16
1,5
19
2
0,05
0,5
0
Изоляты S.aureus в составе биоплёнки наиболее чувствительны к тигециклину (100% исследуемых
изолятов), а также представителям фторхинолонов (ципрофлоксацин – 86% исследуемых изолятов).
32.
Дыхание микроорганизмов– сопряженный окислительновосстановительный процесс, при
котором происходит перенос
электронов и протонов от
окисляемого вещества до
восстанавливаемого, в
результате образуется АТФ
33.
ТИПЫ ДЫХАНИЯоблигатные (строгие) аэробы
облигатные анаэробы
факультативные
(необязательные) анаэробы
микроаэрофилы
34.
Строгие аэробы (Pseudomonas aeruginosa,Bordetella pertussis)
молекулярный кислород – акцептор электронов
АТФ образуется при окислительном
фосфорилировании с участием оксидаз и
флавинзависимых дегидрогеназ с дальнейшим
включением в цикл трикарбоновых кислот
35.
Облигатные анаэробы (Сlostridium tetani,Сlostridium botulinum, Сlostridium perfringens,
бактероиды)
АТФ образуется в результате окисления углеводов,
белков, липидов путем субстратного
фосфорилирования до пирувата (пировиноградной
кислоты)
Акцептором водорода или электронов может быть
сульфат
36.
БРОЖЕНИЕДонорами и акцепторами водорода являются
органические соединения
По конечному продукту расщепления углеводов
различают спиртовое, молочнокислое,
уксуснокислое, муравьинокислое, маслянокислое и
пропионовокислое брожение
37.
Факультативные анаэробы(стафилококки, кишечная палочка)
Образуют АТФ при окислительном и субстратном
фосфорилировании
Акцептором водорода могут быть нитраты, которые
восстанавливаются до молекулярного азота и аммиака
Аэротолерантные бактерии растут при наличии
молекулярного кислорода, но не используют его
38.
Микроаэрофилырастут при сниженном парциальном давлении кислорода
микроаэрофильные аэробы - лучше культивируются
при уменьшенном содержании О2 (около 5%)
микроаэрофильные анаэробы - способны расти в
анаэробных и микроаэрофильных условиях, но не
культивируются в обычной воздушной среде или в
СО2
Капнофильные микроорганизмы - растут в
присутствии повышенных концентраций углекислого
газа (3-5%)
39.
МЕТОДЫ КУЛЬТИВИРОВАНИЯ СТРОГИХ АНАЭРОБОВ1) Посев уколом в высокий столбик сахарного агара, который сверху
заливается слоем вазелинового масла.
2) Посев на среду Китта-Тароцци (МПБ, глюкоза, кусочки печени или
мяса в качестве редуцирующих веществ, сверху среда залита слоем
вазелинового масла).
3) Удаление воздуха из среды механическим путем. Используют
анаэростаты, из которых выкачивается воздух.
4) Замена воздуха другим индифферентным газом (азот, аргон, водород).
5) Механическая защита от кислорода воздуха (метод Виньяль-Вейона).
6) Химическое поглощение кислорода воздуха, (щелочной раствор
пирогаллола).
7) Биологический метод – комбинированный посев анаэробов и аэробов.
40. ФЕРМЕНТЫ БАКТЕРИЙ
биологические катализаторы биохимическихпроцессов
Свойства:
белки,
высокий молекулярный вес,
высокоспецифичны,
быстро действуют,
термолабильны,
способны сохранять свою активность после
гибели клеток
41.
•экзоферменты катализируют процессырасщепления сложных веществ вне клетки
эндоферменты катализируют
метаболизм, проходящий внутри клетки
42.
а) ферменты белкового синтеза –связаны с рибосомами,
б) ферменты энергетического обмена и
транспорта питательных веществ,
располагаются в ЦПМ и мезосомах,
в) ферменты метаболизма белка,
г) ферменты, расщепляющие углеводы
43.
КЛАССЫ ФЕРМЕНТОВ:1) оксидоредуктазы – окислительно-восстановительные ферменты (к
ним относят дегидрогеназы, оксидазы);
2) трансферазы – переносят отдельные радикалы и атомы от одних
соединений к другим;
3) гидролазы – ускоряют реакции гидролиза с присоединением
молекул воды (эстеразы, фосфатазы, глюкозидазы);
4) лиазы – разрывают связи между атомами углерода
негидролитическим путем (карбоксилазы);
5) изомеразы – превращают органические соединения в их изомеры
(фосфогексоизомераза).
6) лигазы – ускоряют синтез сложных соединений из более простых
(аспарагинсинтетаза).
7) транслоказы – катализируют перенос ионов или молекул через
мембраны или их разделение в мембранах.
44.
конститутивные ферменты - синтезируются клеткойпостоянно (лиазы, оксидазы);
индуктивно-адаптивные – синтезируются только в
присутствии субстрата (пенициллиназа, щелочная фосфатаза)
У патогенных микробов есть еще и
ферменты агрессии
способствуют проникновению, распространению и
паразитированию микроорганизмов в макроорганизме
(гиалуронидаза, коллагеназа, нейраминидаза, коагулаза,
ДНКаза)
45.
ЗНАЧЕНИЕ ФЕРМЕНТОВ1) катализируют процессы дыхания, питания, размножения;
2) используются в диагностике при определении вида
возбудителя по биохимическим свойствам;
3) применяют в генной инженерии (рестриктазы, лигазы);
4) используют для получения уксусной, молочной, лимонной и
других кислот, молочнокислых продуктов, в виноделии;
5) применяют в качестве биодобавок в стиральные порошки
для уничтожения загрязнений белковой природы
46. БИОХИМИЧЕСКИЕ СВОЙСТВА БАКТЕРИЙ
Каждый вид микроба обладает определеннымнабором ферментов, что обусловлено генотипом. Это
используют для дифференцировки бактерий.
Расщепление углеводов (глюкоза, лактоза,
сахароза, мальтоза и др.) определяют при помощи
сред Гисса. Углеводы могут расщепляться до кислых
продуктов (определяются индикатором) и газа (в
поплавке или по разрыву полужидкой среды).
47. Среды Гисса
48.
Расщепление белков определяют:по конечным продуктам – индол, аммиак,
сероводород – применяют специальные
индикаторы (щавелевая кислота, лакмус,
сернокислый свинец);
по разжижению желатина;
по свертыванию молока
49. БАКТЕРИОСКОПИЧЕСКИЙ МЕТОД
Ориентировочный!Определяют:
морфологические свойства (форма
клеток, размеры, взаимное расположение
в мазке)
тинкториальные свойства (способность
по-разному окрашиваться различными
красителями)
50. БАКТЕРИОЛОГИЧЕСКИЙ МЕТОД
1. Выделение чистой культуры2. Идентификация по морфологическим,
тинкториальным,
культуральным,
биохимическим,
антигенным свойствам

Биология
Биология








